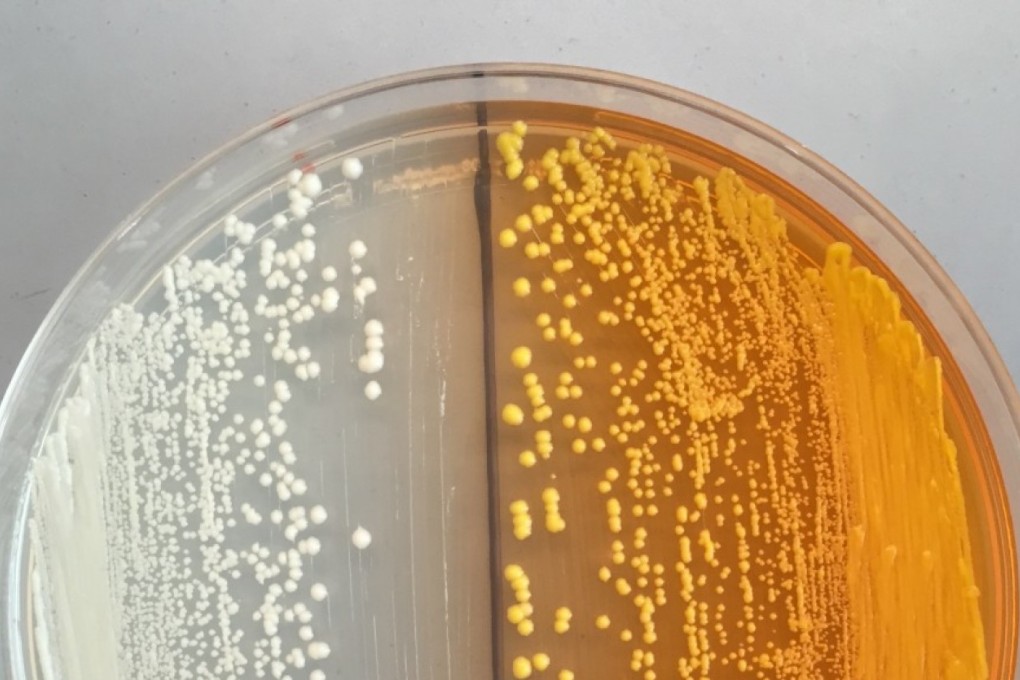
Genetically modified yeast like this can form the basis for laboratory-grown opiates. Photo: Washington Post

Scientists finish recipe for homebrewed heroin using genetically modified yeast
Scientists have figured out all the steps to make morphine and similar painkillers without using opium poppies, opening the door for homebrewed drugs and even wider abuse.
While no one has yet reported making morphine in the laboratory from scratch, some experts are calling for regulations to prevent garage tinkerers from making do-it-yourself morphine, which can be converted into heroin.
Society needs to “think this through now before it becomes a reality,” said bioengineer John Dueber of the University of California, Berkeley, who led a team that discovered the final missing link of the process.
Poppy plants have been farmed for centuries for opium, from which morphine is derived. The controlled substance is often used before and after surgeries to relieve severe pain.
For the past decade, various groups of researchers have hacked the DNA of yeast to mimic poppies, in hopes of creating cheaper and less addictive pain relievers. So far, the yeast strains created can only perform the last steps of a long process that can lead to morphine and other narcotic drugs.
But a team led by researchers at UC Berkeley discovered the missing piece — the first step in the process — and published the findings Monday in the journal Nature Chemical Biology.
The genetically engineered yeast was able to convert sugar to a chemical that’s a precursor to morphine. While the researchers stopped short of producing the drug in the lab, their work lays the foundation for DIY narcotics without the need to grow poppies.